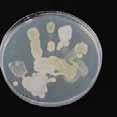

![]()
















9” Unit of 10
7”- 9” Unit of 50 EW0709F $23.40 9”- 12” Unit of 10 EW0912J
9”- 12” Unit of 50 EW0912F $27.00 12”- 15” Unit of 10 EW1215J $7.10 12”- 15” Unit of 50 EW1215F $34.00















We developed this kit after visiting with several teachers at various trade shows. They mentioned how students always want to bring a specimen to class or collect specimens. This kit contain the basic collection supplies needed to preserve and label a specimen. It also contains a sample STEM lesson plan which can be expanded or deviated from into hundreds of areas. That is what is so awesome about this STEM kit. The students work in separate groups but it is a total team effort to develop a new product.
specimen collection kit contains: 1 quart of embalming fluid
8 oz. jar, 6 oz. jar, 2 oz. jar, labels 20 mil jar, Gloves (large) Tweezers, Lesson Plan
This Kit can be used for several STEM projects and many different specimens can be collected to learn from.











Comparative Kit
Discover the similarities and differences between the 4”-5” plain preserved Bullfrog and the 5”+ plain preserved Leopard Frog. LB08P $15.60/kit

Comparative Kit
Discover the similarities and differences of the 4”-4.5” plain preserved Leopard Frog and plain preserved Salamander.
AK020P $9.60/kit


4” - 4.5”
These dissection packets are intended to guide the student through dissection in a step-by-step manner. Instructions are intended for the instructor to demonstrate for the student. Illustrations will aid in the identification of structures.
Figures have been designed in a manner in which the answers to the numbered structures can be covered up for quiz purposes.
A worksheet is located in the back of the guide along with an answer key.



Pail packed sharks are available ONLY in quantities of 10 or more for an additional $1.40 per specimen. Please indicate with an extra “P” at the end of Item ID. Pregnant sharks are NOT available in pail packs and are seasonal. Stock does run out.
*While Supplies Last Economy Shark FSK001P* $6.50
The economy shark is a failed injection. There may be latex spread throughout the shark. The specimen is still in perfect condition. For an inexpensive shark dissection try our economy sharks.
A GREAT NEW TOOL TO HELP YOU IN THE LAB!
Supplies Last Shark Pup
These fully illustrated guides have been created to give you and your students a full color, step-by-step reference when performing dissections.

Designed to guide you and your students through dissection. Full color photographs and illustrations identify all major systems and structures. Each set of 8.5” x 11” double sided sheets are laminated for durability and bound together with metal book rings for ease of use in the lab.



























Pig Bladder
VacPac P005P 1-9 10-99
100+
Pail Pack P005PP 10-99
100+
Pig Brain
with cranial nerves, optic chiasma, hypo. and dura. VacPac P001P 1-9 10-99
100+
Pail Pack P001PP 10-99 100+
Pig B rain economy
VacPac P000P 1-9 10-99
100+
Pail Pack P000PP 10-99 100+
Pig e ye
VacPac P010P 1-9 10-99 100+
Pail Pack P010PP 10-99 100+
Pig Heart - Plain VacPac P015P 1-9
Pail Pack P015PP



Pig Heart in Pericardium VacPac P020P
Pail Pack P020PP
Pig Kidney - Plain VacPac P025P
Pail Pack P025PP
Pig Kidney - Single VacPac P030S
Pail Pack


Pig Kidney - d ou B
Pail Pack P035DP




























Pail Pack S070PP 10-99

SHEEP u TER u S (not pregnant) VacPac S075P 1-9 10-99
Pail Pack S075PP 10-99
SHEEP u TER u S - PREG n A n T
S080P 1-9


SHEEP PL u CK VacPac S060P 1-9 $12.30 10-99 $12.20
SHEEP PL u CK WITHO u T LIVER VacPac S061P 1-9














calf heart, beef kidney (plain), cow brain, and a beef eye. Item ID 1-9
Sheep heart (uncut), sheep kidney, sheep brain in dura, and a sheep eye.
ID 1-9
9”-11” plain preserved fetal pig, pig heart (plain), pig kidney plain, pig brain, and a pig eye.
Compare the pregnant pig uterus (1” - 3” embryos) to the pregnant sheep uterus.
This set of brains (from a sheep, a pig, and a cow) comes with a guide on the mammalian brain. Each brain retains the meninges, the optic chiasma, and the pituitary gland.
Dissect the sheep heart, the pig heart, and the calf heart (w/o peri). Use the included guide for the mammalian heart.
Brain SHEEP Cla SS S E t w/o hypo CSSB01P $140.00
BU ll F r OG Cla SS S E t 5” - 6” CSBF01P $157.40
C at C la SS SE t 14” - 18” CSCT01P ... $607.10
Cat (S kinn E d) Cla SS S E t 14” - 18” CSSC01P ... $665.30
Clam Cla SS S E t 4” - 5” CSCL01P ...... $29.48
Cray F i SH Cla SS S E t 4” - 6” CSCF01P

Pail Packed specimens are in holding fluid. Additional fluid can be purchased by the gallon.


- L ARGE
Each kit contains ten:
4” - 6” Crayfish (plain)
9” - 12” Earthworms
4” - 5” Clams
4” - 4.5” Leopard Frogs (plain)
7” - 9” Yellow Perch (plain)
4” - 6” Starfish (plain)
Grasshoppers (plain)
9” - 11” Fetal Pigs (plain)
22” - 27” Dogfish Sharks (plain)
8” - 12” Squid (plain)
BDK010L VacPac
each kit
10 or more kits (ea)
$403.66
$399.61
BDK010LP Pail Packed each kit
$449.75
10 or more kits (ea) $445.25
- E XTRA L ARGE
Each kit contains ten:
4” - 6” Crayfish (plain)
12” - 15” Earthworms
5” - 6” Clams
5” + Leopard Frogs (plain)
9” - 12” Yellow Perch (plain)
6” - 8” Starfish (plain) Grasshoppers (plain)
14” - 17” Fetal Pigs (plain)
27” + Dogfish Sharks (plain)
12” - 16” Squid (plain)
BDK010D VacPac each kit
$555.84
10 or more kits (ea) ......... ..$550.28
BDK010DP Pail Packed each kit
$605.69
10 or more kits (ea) ......... ..$600.76
Each kit contains ten:
4” - 6” Crayfish (plain)
9” - 12” Earthworms
4” - 5” Clams
4” - 4.5” Leopard Frogs (plain)
7” - 9” Yellow Perch (plain)
4” - 6” Starfish (plain)
- E
Each kit contains ten:
4” - 6” Crayfish (plain)
12” - 15” Earthworms
5” - 6” Clams
5” + Leopard Frogs (plain)
9” - 12” Yellow Perch (plain)
6” - 8” Starfish (plain)
Each kit contains ten:
4” - 6” Crayfish (plain)
9” - 12” Earthworms
4” - 5” Clams
4” - 4.5” Leopard Frogs (plain)
7” - 9” Yellow Perch (plain)
4” - 6” Starfish (plain) Grasshoppers (plain)
Each kit contains ten:
4” - 6” Crayfish (plain)
12” - 15” Earthworms
5” - 6” Clams
5” + Leopard Frogs (plain)
9” - 12” Yellow Perch (plain)
6” - 8” Starfish (plain) Grasshoppers (plain)
or more kits (ea)
Each kit contains ten:
4” - 6” Crayfish (plain)
9” - 12” Earthworms
4” - 5” Clams
4” - 4.5” Leopard Frogs (plain)
7” - 9” Yellow Perch (plain)
4” - 6” Starfish (plain)
Grasshoppers (plain)
9” - 11” Fetal Pigs (plain)
Each kit contains ten:
4” - 6” Crayfish (plain)
12” - 15” Earthworms
5” - 6” Clams
5” + Leopard Frogs (plain)
9” - 12” Yellow Perch (plain)
6” - 8” Starfish (plain) Grasshoppers (plain) 14” - 17” Fetal Pigs (plain)
- L ARGE
Each kit contains one:
4” - 6” Crayfish (plain)
9” - 12” Earthworm
4” - 5” Clam
4” - 4.5” Leopard Frog (plain)
7” - 9” Yellow Perch (plain)
4” - 6” Starfish (plain)
DK0006L VacPac
Each kit contains one:
4” - 6” Crayfish (plain)
12” - 15” Earthworm
5” - 6” Clam
5” + Leopard Frog (plain)
9” - 12” Yellow Perch (plain)
6” - 8” Starfish (plain)
- L ARGE
Each kit contains one:
4” - 6” Crayfish (plain)
9” - 12” Earthworm
4” - 5” Clam
4” - 4.5” Leopard Frog (plain)
7” - 9” Yellow Perch (plain)
4” - 6” Starfish (plain) Grasshopper (plain) DK0007L
Each kit contains one:
4” - 6” Crayfish (plain)
12” - 15” Earthworm
5” - 6” Clam
5” + Leopard Frog (plain)
9” - 12” Yellow Perch (plain)
6” - 8” Starfish (plain) Grasshopper (plain)
DK0007D
DK0007DP Pail Packed 10 or more kits (ea)
- L ARGE
Each kit contains one:
4” - 6” Crayfish (plain)
9” - 12” Earthworm
4” - 5” Clam
4” - 4.5” Leopard Frog (plain)
7” - 9” Yellow Perch (plain)
4” - 6” Starfish (plain) Grasshopper (plain)
9” - 11” Fetal Pig (plain)
DK0008L VacPac
Each kit contains one:
4” - 6” Crayfish (plain)
12” - 15” Earthworm
5” - 6” Clam
5” + Leopard Frog (plain)
9” - 12” Yellow Perch (plain)
6” - 8” Starfish (plain) Grasshopper (plain)
14” - 17” Fetal Pig (plain)
DK0008D
DK0008DP Pail Packed 10 or more kits (ea)
- M EDIUM
Each kit contains one:
9” - 12” Earthworm
7” - 9” Rat (plain)
4” - 4.5” Leopard Frog (plain)
7” - 9” Yellow Perch (plain) DK0004P
Each kit contains one:
4” - 6” Crayfish (plain)
9” - 12” Earthworm
4” - 5” Clam
4” - 4.5” Leopard Frog (plain)
7” - 9” Yellow Perch (plain)
4” - 6” Starfish (plain)
Grasshopper (plain)
9” - 11” Fetal Pigs (plain)
22” - 27” Dogfish Shark (plain)
8” - 12” Squid (plain)
Each kit contains one:
4” - 6” Crayfish (plain)
12” - 15” Earthworm
5” - 6” Clam
5” + Leopard Frog (plain)
9” - 12” Yellow Perch (plain)
6” - 8” Starfish (plain) Grasshopper (plain)
14” - 17” Fetal Pig (plain)
27” + Dogfish Shark (plain)
12” - 16” Squid (plain)
DK0100D VacPac
Kit $55.58
or more kits (ea) $55.02 DK0100DP
1 Double Injected 11”-13” Preserved Fetal Pig
1 13”x8” Reusable Styrofoam Pan
1 Student Dissecting Equipment Kit #4
1 Fetal Pig Dissection Reference Guide
1 12”x24” Storage Bag, ID Tag, Rubber Band
Item ID 1-9 10+
BOXFP01X $32.05 $31.10
1 Double Injected 22”-27” Preserved Shark
1 Shark Pan
1 Student Dissecting Equipment Kit #4
1 Shark Dissection Reference Guide
1 12”x36” Storage Bag, ID Tag, Rubber Band
Item ID 1-9 10+
BOXSH01X $50.26 $47.94
1 Double Injected 4”-4.5” Preserved Frog
1 13”x8” Reusable Styrofoam Pan
1 Student Dissecting Equipment Kit #4
1 Frog Dissection Reference Guide
1 12”x12” Storage Bag, ID Tag, Rubber Band
Item ID 1-9 10+
BOXFR01X $21.00 $20.50
1 Double Injected 18”-23” Preserved Cat
1 Large Animal Pan and Pad
1 Student Dissecting Equipment Kit #4
1 Cat Dissection Reference Guide
1 12”x36” Storage Bag, ID Tag, Rubber Band
IN-A-BOX kit with out the pan/pad
Item ID ea CTBOX01X $58.03
1 Double Injected 7”-9” Preserved Rat
1 13”x8” Reusable Styrofoam Pan
1 Student Dissecting Equipment Kit #4
1 Rat Dissection Reference Guide
1 12”x12” Storage Bag, ID Tag, Rubber Band
Item ID 1-9
BOXRT01X $27.86


1 13”x 8” Reusable Styrofoam Pan
1 Student Dissecting Equipment Kit #4
20 Plain T-Pins
2 Pairs of Disposable Latex Gloves
1 White Disposable Apron
1 Student Packet, Worksheet and Answer Key
1 Preserved 7”-9” Yellow Perch Specimen
Beginner • plain • Grades 3-6
Item ID: HBYP0709P
Intermediate • plain • Grades 7-9
$12.10
Item ID: HIYP0709P ................ $12.10
Advanced • plain • Grades 9-12
Item ID: HAYP0709P $12.10
1 13”x 8” Reusable Styrofoam Pan
1 Student Dissecting Equipment Kit #4
20 Plain T-Pins
2 Pairs of Disposable Latex Gloves
1 White Disposable Apron
1 Student Packet, Worksheet and Answer Key
1 Preserved 9”- 12” Earthworm Specimen
Beginner • plain • Grades 3-6
Item ID: HBEW0912P .............
$10.83
Intermediate • plain • Grades 7-9
Item ID: HIEW0912P $10.83
Advanced • plain • Grades 9-12
Item ID: HAEW0912P ............. $10.83
1 13”x 8” Reusable Styrofoam Pan
1 Student Dissecting Equipment Kit #4
20 Plain T-Pins
2 Pairs of Disposable Latex Gloves
1 White Disposable Apron
1 Student Packet, Worksheet and Answer Key
1 Preserved 4”-4.5” Leopard Frog Specimen (Appropriate Injection for Level)
Beginner • plain • Grades 3-6
Item ID: HBLF0445P ............... $14.25
Intermediate • single • Grades 7-9
ID: HILF0445S $14.50 Advanced • double • Grades 9-12
ID: HALF0445D ............... $14.85
1 13”x 8” Reusable Styrofoam Pan
1 Student Dissecting Equipment Kit #4
20 Plain T-Pins
2 Pairs of Disposable Latex Gloves
1 White Disposable Apron
1 Student Packet, Worksheet and Answer Key
1 Preserved 7”-9” or 9”-11” Fetal Pig Specimen (Appropriate Injection for Level)
Beginner • plain • Grades 3-6 Item ID: HBFP0709P ............... $18.69 Intermediate • single • Grades 7-9
ID: HIFP0911S $23.85
Advanced • double • Grades 9-12 Item ID: HAFP0911D ............... $22.99
For your convenience, Bio Corporation has put together a variety of kits, specifically designed for individuals.
IN-A-BOX kits provide everything needed to perform an advanced dissection. These kits include a step-by-step Dissection Reference Guide, dissection pan, dissection tools, specimen, storage bag, rubber band and ID tag.

INDIVIDUAL SPECIMEN kits were designed to be cost efficient, fun and easy to use. Beginner, intermediate and advanced levels available, with the
Earthworm, Leech, Nereis
Anolis Lizard, Baby Chick, Pig Embryo, Grassfrog, Mouse VjS414V........$29.05
Grasshopper, Walking Stick, Dragonfly, Giant Water Bug, Millipede, Butterfly, Centipede, Cockroach
IjS313I..........$41.68


PORIFERA:
NEMATODA: Ascaris
MOLLUSCA: Clam
Octopus
ANNELIDA: Earthworm
ARTHROPODA: Butterfly
Centipede Crayfish Grasshopper June Beetle Millipede Tarantula
ECHINODERMATA: Sea Cucumber Sea Urchin Starfish
CHORDATA: Amphioxus Baby Chick Grassfrog Shark Pup

Clam, Octopus, Chiton, Snail-Helix




Crayfish, Goose Barnacle, Sow Bug, Tarantula

Brittle Star, Sea Cucumber, Sea Urchin, Starfish




LATEX GLOVES
please check LG0607S small website for LG0708M medium current prices LG0809L large LG0910X extra large
NITRILE GLOVES powder free, textured please check PR0607S small website for PR0708M medium current prices PR0809L large
SYNTHETIC GLOVES powder free please check Y201 small website for Y202 medium current prices Y203 large Y204 extra large HEAVY LATEX
$1.00/pair
EG0607S small
Contains one blue vinyl apron, one pair of heavy reusable gloves and one pair of clear soft molded vinyl goggles. Item ID Size each SE00001 small

R IMLESS
Anti-scratch, fogless, anti-static, with UV protection. Adjustable sides to fit almost everyone.
1-9 10+
C LEAR S OFT M OLDED V IN y L G OGGLES
Lightweight with excellent side protection. Fits over most prescription lenses, protects best against flying materials.
EG0708M medium
EG0809L large





Each bag includes a student ID tag & a rubber band.
ITEM ID PKG Compatible with #10 SL0100X 10 PKG $3.00 #3 handle #10 SL0100B 100 PKG $15.00 #3 handle #11 SL0110X 10 PKG $3.00 #3 handle #11 SL0110B 100 PKG $15.00 #3 handle #12 SL0120X 10 PKG $3.00 #3 handle #12 SL0120B 100 PKG $15.00 #3 handle #15 SL0150X 10 PKG $3.00 #3 handle #15 SL0150B 100 PKG $15.00 #3 handle
#20 SL0200X 10 PKG $3.00 #4 handle #20 SL0200B 100 PKG $15.00 #4 handle #21 SL0210X 10 PKG $3.00 #4 handle #21 SL0210B 100 PKG $15.00 #4 handle #22 SL0220X 10 PKG $3.00 #4 handle #22 SL0220B 100 PKG $15.00 #4 handle #23 SL0230X 10 PKG $3.00 #4 handle #23 SL0230B 100 PKG $15.00 #4 handle #24 SL0240X 10 PKG $3.00 #4 handle #24 SL0240B 100 PKG $15.00 #4 handle




#25 SL0250X 10 PKG $3.00 #4 handle #25 SL0250B 100 PKG $15.00 #4 handle


High carbon steel blade is mounted on a plastic handle, individually foil wrapped and sterilized by gamma radiation. Box of 10
Clear plastic 4.5” in length. Features dual lenses of 3x and 6x. 3x lens is 50mm in diameter. 6x lens is 30mm in diameter Item ID Each MG01 $1.00


includes one each: folding case, #4 handle, compatible blade, 5.5” straight scissors, 5.5” straight forceps, bent teasing needle, straight teasing needle, pipette, and ruler.
DEK001P $6.50
includes one each: folding case, #4 handle, compatible blade, 5.5” straight scissors, 5.5” straight forceps, 5.5” curved forceps, bent teas- ing needle, straight teasing needle, pipette, and ruler.
DEK002P $8.50
includes one each: folding case, #4 handle, #3 handle, compat- ible blades, 5.5” straight scissors, 5.5” curved scissors, 5.5” straight forceps, 5.5” curved forceps, bent teasing needle, straight teasing needle, mall probe, and ruler.
DEK003P $11.25
includes one each: folding case, #4 screw-lock handle, compatible blade, 4.5” dissecting scissors, 4.5” straight forceps, bent teasing needle, straight teasing needle, pipette, and ruler.
DEK004P $5.40



includes one each: folding case, #4 handle, #3 handle, compatible blades, cartilage knife, 4.5” iris scissors, 5.5” straight scissors, 4.5” straight medium point forceps, 4.5” straight fine point forceps, bent teasing needle, straight teasing needle, probe and seeker, blow pipe, triple hook and chain, and ruler.
DEK005P $14.50
BASIC DISSECTING KIT
includes one each: soft case, cartilage knife, 4.5” dissecting scissors, 4.5” straight forceps, 6 T-Pins, pipette, and ruler.
DR-64 $5.95
includes one each: plastic case, #4 screw-lock scalpel, compatible blade, 4.5” dissecting scissors, 4.5” straight forceps, bent teasing needle, straight teasing needle, pipette, and ruler.
DR61PC $6.10
includes one each: folding case with zipper, cartilage knife, 4.5” dis- secting scissors, 4.5” straight forceps, bent teasing needle, straight teasing needle, pipette, and ruler.
DR60zP $6.15
includes one each: plastic case, #4 screw-lock scalpel, compatible blade, 4.5” iris scissors, 4.5” straight forceps, straight teasing needle, pipette, and ruler.
DR-61936PCT $8.05
SUPER DISSECTING KIT
includes one each: folding case, #3 handle, #4 handle compatible blades, cartilage knife, 5.5” straight scissor, 4.5” iris scissors, 4.5” fine point straight forceps, 5.5” straight forceps, bent teasing needle, straight teasing needle, probe and hook, chain and hook, blow pipe, ruler, and “How to Dissect” book covers dissections with illustrations of: Earthworm, Crayfish, Grasshopper, Clam, Squid, Starfish, Dogfish Shark, Perch, Frog, Fetal Pig and Gladiolus. DR-5-101 $30.75


includes equipment storage tray with lid, (15) #4 handles, (20) #24 blades, (15) 5.5” straight scissors, (15) straight forceps, (12) bent teasing needle, (12) straight teasing needle, 1 ½ lbs. box 2” t-pins.
DEK006P $92.75




DPCT001C Polyethylene large pan/pad/cover* $52.40 DPCT001X Polyethylene large pan/pad* $39.90



T-PINS

1-9 10+
$0.60 $0.50


BPP01X 3.5” Unit of 100 $4.00
All pellets have been heat-treated for 20 minutes at 325º F. which has been confirmed to kill bacteria. Wearing gloves and washing hands are good practice and will also teach students good laboratory/safety habits.
On rare occasions students who are allergic to pets may have a reaction from owl pellets. Owl pellets contain hair of the prey, so it is a good idea to ask if any students are allergic to pets before dissection.









Clear plastic magnifier is 110 mm (4.50”) in length and features dual lenses of 3x and 6x magnification. 3x is 50mm in diameter and 6 x is 20mm.


Contains a food chain chart, 15 key to skulls of common barn owl prey sheets, 15 vole and shrew skeletal anatomy sheets, 15 identify owl pellet contents sheets, 20 toothpicks, 15 rulers, 15 owl pellets, 15 lab worksheets, and the Owl Pellet Dissection Reference Guide.
OWKT01X $101.00
Learn about this magnificent animal’s habitat. This great pre-lab video goes through the owl life cycle and discusses the owls ability to see at night. Learn about the food chain and the nature of the predator/prey relationship.
Contains 15 owl pellets and the Owl Pellets Dissection Reference Guide.
Contains a food chain chart, 30 reference guides, 30 paddle picks, 30 rulers, 30 owl pellets, 30 magnifiers, 30 bone keepers, 30 student tweezers.
DOPS01X $317.50
W LID
BK005Z 0.5 oz. unit of 30 $1.25










Bat Skeleton CA-51010 ........ $60.35
Bullfrog Skeleton CA-51011 $52.01
Cat Skeleton CA-51009 ...... $139.91
Cat Skeleton (disarticulated) CA51509 ....... $101.41
Chicken Skeleton CA-51008 ...... $148.54
Chicken Skeleton (disarticulated) CA51508 ....... $128.31
Dog Skeleton CA-51014 $442.85
Dog Skeleton (disarticulated) CA-51514 ...... $347.04
Fish Skeleton CA-51001 ........ $53.03
Lizard Skeleton CA-51007 $59.74
Non-Venomous Snake Skeleton CA-51016 ........ $54.85
Venomous Snake Skeleton CA-51006 $62.88
Pigeon Skeleton CA-51003 ........ $96.38
Pigeon Skeleton (disarticulated) CA51503 ......... $70.75
Rabbit Skeleton CA-51004 $111.20
Rat Skeleton CA-51012 ........ $62.62
Toad Skeleton CA-51002 $54.38
Turtle Skeleton CA-51005 ........ $75.84
Turtle Natural Shell Skeleton CA-51005N...... $78.03
Quail Skeleton CA-51019 $65.23





1” x 3” high quality glass with uniform thickness 1.0-1.22mm and no bubbles or striations. The edges are ground smooth.


MICROSCOPE SLIDES 144/pack
These 1” x 3” plastic microscope slides are made from optically clear vinyl. They will not break or scratch. SS-B10675-S3
Skull Comparison CA-51020 ...... $83.67
Front Limb Comparison CA-51021 $83.67
Hind Limb Comparison CA-51022 ...... $83.67
Spinal Column Comparison CA-51023 ...... $83.67
Set of all 4 Comparison CA-51024 $290.46


Our skeleton specimens are real animal bones, cleaned and specially treated. Each specimen is articulated in a natural posture and mounted on a finished wooden base with removable clear acrylic cover.

SKULL
includes bottom jaw STSKULLS $22.75
COVER GLASS 100/pack
18x18mm no.1 high quality glass with uniform thickness. SS-B10684-S3 $2.99
COVER SLIP 100/pack
18x18mm Great alternative to glass cover slips, these plastic cover slips are unbreakable, flexible, and non-curling.
SS-B10698A-S3 $3.99
Slide Box
Plastic, compact, holds slides 75x25mm, vertically in prenumbered grooves, provided with index card.
SS-B10756 $5.99






•Supports STEM (science, technology, engineering, and math) learning and fun!
•10X eyepiece 4X, 10X, 40X Objectives
•40X, 100X & 400X Magnification
•Real optical glass lenses
•Dual focusing knobs
•2 LED lights, above and below
•Uses 3 AA batteries (not included)
•CE Certified
•CPSIA approved
•50 accessories included
Two light sources allow this microscope to magnify both slides and solid objects! you would need two instruments to view what this one does — a basic biological scope to look at specimens on a slide (light shines up from under the slide and through the tissue) and a traditional stereo or dissecting microscope to view solid objects at lower power (light shines down onto the specimen to be observed). This new Duo Scope with dual lighting allows for both types of applications! Cordless battery power makes it possible for field study. Priced to fit any budget with the same fine quality as other scopes.
The upgraded MS-03L is equipped with four DIN objectives including 100x oil immersion and comes standard with mechanical stage slide holder for a full featured, reliable instrument at a fraction of the cost of professional scopes. Features:
10X Eyepiece with scale pointer
Monocular head rotatable 360°
DIN Achromatic parfocal and parcentered Objectives 4X, 10X, 40XR & 100XR (oil)
Total 40X to 1000X magnification
Coarse & fine controls
Spiral condenser N.A.1.25 with iris diaphragm
20W tungsten lamp
Vinyl dust cover, spare bulb & immersion oil
CE Certified
Variable intensity 5.5V LED cool illumination system
Built in rechargeable battery with detachable AC power cord
Advantage of LED illumination:
Life time of LED bulb is 100,000 hours
LED consumes very little power
Fully charged battery provides up to 15 hours of normal use
Versatile power allows cordless use for portability
Cool LED prevents focus deviation caused by heat-deformed equipment CE Certified
The detachable AC power cord can be used to power the light or recharge the battery for portable use “in the field”. Battery lasts for hours and can be recharged hundreds of times for years of valuable scientific research!
10X Widefield eyepiece with pointer
3 Achromatic objective lenses: 4X, 10X & 40X Power
Magnification from 40X to 400X
Adjustable LED illumination
6 Hole disc diaphragm
Built in rechargeable battery & detachable AC power cord
Includes five prepared slides
Advantages of LED illumination: Life time of LED bulb is 100,000 hours
LED consumes very little power
Fully charged battery provides up to 15 hours of normal use
Versatile power allows cordless use for portability
CE Certified
DELUXE SLIDE MAKING KIT/GLASS kit includes:
12 glass slides
12 glass cover slips
3 glass slides w single concavity
1 storage case
4 petri dishes (35 mm)
plastic forceps
plastic pipette
gum media
25 labels preparation guide
SS-PH96001-S3 $16.99
kit includes:
12 plastic slides
12 plastic cover slips
3 plastic slides w single concavity
1 snap box
4 petri dishes (35 mm)
plastic forceps
plastic pipette
gum media
25 labels preparation guide
SS-PH96002-S3 $16.99


PREPARED SLIDE SET
Handmade Paper Wool
Synthetic Nylon
Bemberg De Chine
Silkworm Nest
Panya Fiber
Angora Rabbit
Camel Hair
Sheep Hair Manufactured
Hemp Fiber
Cotton Fiber
Silk Fiber
SS-B14050-S3 $24.00
PREPARED SLIDE SET
Locust Wing
Cicada Wing
Dragon Fly Wing
Butterfly Scale
Leg of Butterfly
Butterfly Wing
Antenna of Butterfly
Leg of Honeybee
Bee Abdomen
Worker Bee Wing
Honeybee Compound Eye
Bee Antenna
SS-B14035-S3 .... $24.00
PREPARED SLIDE SET
Sheep Hair Manufactured
Feather Fowl point
Goldfish Scale
Striated Muscle of Frog
Canary Feather
Pheasant Fur
Hare Hair
Fox Hair
Mouse Fur
Cat Hair
Dog Hair
Horse Hair
SS-B14030-S3 $24.00
PREPARED SLIDE SET
Marine litral diatoms
Volvox
Water worm
Chroococcus
Freshwater plankton
Marine plankton
Cosmarium
Microcytis
Spirulina
Microcytis
Frog embryo, cleavage stage
Rabiolaria
SS-B14005-S3 .... $45.99
PREPARED SLIDE SET
Spore of Lycopodium
Penicillium Notatum
Aspergillus Niger
Fern Spore
Bottle Brush Spore
A Leaf Spore
Pine Tree Pollen
Pumpkin Pollens
Pollen of Lily
Sunflower Pollen
Chrysanthenmum Pollen
Tulip Pollen
SS-B14040-S3 $24.00
PREPARED SLIDE SET
Shrimp Eggs
Silk Worm larvae (moth)
Fruit Fly
Chironomus Larvae
Plant Louse
Water Flea
Microcytis
Anabaena
Scenedesmus quadn cauda
Nematoda
Paramecium, w.m.
Rabiolaria
SS-B14015-S3 .... $45.99
PREPARED SLIDE SET
Spirogyra vegetative stage
Navicula
Pinnularia
Euglena
Cosmarium
Cymbella
Anabaena
Oscillatoria
Synedra
Melosira
Hydrodictyon
Chlorella
SS-B14010-S3 .... $45.99
PREPARED SLIDE SET
Pseudomonas aeruginosa
Escherichia Coli
Rhizobium radicicola
Bacterium brasicae fermentatae
Neisseria gonorrioeae
Bacillus subtills
Micobacterium tuberculosis
Streptococcus
Dysentery bacilli
Corynebacterium diphtheria
Vibrio verolinensis
Bacteria in buccal cavity
SS-B14001-S3 $46.39
PREPARED SLIDE SET
Silver Berry Scaly Hair
Onion Rind
Fern Spore
Herbaceous Stem of Bitterweed
Voluble Stem of Sponge Gourd
Xeromorf Leaf of Nerium
Monocotyledonous Stem of Corn
Dandelion Ear
Tree Cell
Camellia Leaf Section
Woody Stem of Pine
Pine Needle c.s.
SS-B14045-S3 .... $24.00
PREPARED SLIDE SET
Ulotrichaceae
Pandorina
Placoid scale of shark
Fish scale w.m.
Frog embryo, cleavage stage
Pediastrum
Ulva comglobata
Thallus of Ulva
Common Red Spounge
Gelidium Plant
Paramecium, w.m.
Rabiolana
SS-B14020-S3 .... $45.99
Designed by a science teacher for educators. Never before has it been so easy to view a wet micro organisms, including bacteria, fungi and protists. •Uniform depth of large viewing well is 0.23mm and perfect for maintaining a shallow depth of field •Innovative configuration has partitions to keep specimens in the viewing area allowing for easy tracking •Optically clear slide made of Makrolon® polycarbonate making it durable and reusable •Excellent impact resistance for safe use both indoors and outdoors •Can be used as a traditional slide providing for dual-purpose use •Can be used with traditional and digital microscopes offering versatility •Includes 2 reusable coverslips made of Makrofol® (0.13mm and 0.25mm)
LS-18IM $1.99 each liveslide w/2 coverslips
LS-CS1805 $5.55 5 sets of 2 replacement coverslips


Each set includes five related prepared slides and an insert which describes the specimens and offers some information. Blood and Guts
BUGS # 1
Scorpion, Giant Ant, Wasp, Flower Bug in acrylic blocks.
CA-MASB3.......... $11.25
BUGS # 2
Cricket, Locust, Yellow Leaf Beetle, Crab in acrylic blocks.
CA-MASB4 $11.25
Cotton Fibers
Nylon Fibers
Corn Starch
Salt Crystal
Wool Fibers
Silk Fibers
Steam of Pumpkin c.s
Legs of Honey Bee
Pollen
Bird Feather
Hydra w.m
Frog blood smear CA-PS01
INTERMEDIATE PREPARED SLIDE SET
Hair
Sugar
Pepper
Yeast w.m
Tendon l.s
Bacteria 3 Types
Fly Head
Fish Skin
Human Blood smear
Paramecium w.m
Wing of House Fly
Cotton Stem c.s
Cotton Leaf c.s
Penicillium Section
Hydra l.s
Lily Anther
Sprout l.s
Monocotyledon Stem c.s
Dicotyledon Stem c.s
Simple Squamous Epithelium
Stratified Squamous Epithelium
Cardiac (heart) Muscle
Smooth Muscle
Mammal Testes
Ovary

HIGH SCHOOL PREPARED
SLIDE SET
Loose Connective Tissue
Spinal Cord c.s
Motor Nerve Ending
Mammal Stomach Section
Kidney c.s
Artery & Vein c.s
Blood Vessel of Lung
Blood Vessel of Kidney
Taste Bud
Mouth smear
Human Sperm smear
Mitosis of Animal Cell
Hydra thru Testis c.s
Hydra thru Ovary c.s
Hydra with Bud
Fern Prothallium w.m
Zea Mays Seed l.s
Spirogyra
Mammal Lung
Mammal Colon
Mammal Trachea
Mammal Pancreas
Mammal Uterus
Mammal Spleen
Onion Root Tips
CA-PS03 ............. $35.54
BIOLOGY PREPARED
SLIDE SET
Amoeba Proteus
Euglena
Diatoms
Ascaris Mitosis
Grantia Spicules
Hydra, budding
Leaf with Vein c.s
Paramecium w.m
Onion Root Tip
Planaria w.m
Ranunculus Root c.s
Ranunculus Stem c.s
Spirogyra
Volvox
Zea Mays Root c.s
Zea Mays Stem c.s
CA-PS16 ............. $36.87


SS-T001 MicroSlidE-ViEwEr $22.99
SS-T010 CELLS OF YOUR BODY SET
SS-T011 CELLS OF PLANTS SET
SS-T016 FROM A TADPOLE TO A FROG
SS-T017 CHICK EMBRYO SET SET
SS-T018 INSECT PARTS SET
SS-T019 HELPFUL BACTERIA (2000X) SET
SS-T020 HARMFUL BACTERIA (2000X) SET
SS-T050 ANIMAL TISSUES-A SET/8
SS-T051 ANIMAL TISSUES-B SET/8
SS-T053 ANIMAL MITOSIS SET
SS-T055 PLANT MITOSIS
SS-T058 CELL STRUCTURE
SS-T059 PHOTOSYNTHESIS SET
SS-T060 CLEAVAGE
SS-T062 REPRODUCTION SET
SS-T063 ASEXUAL REPRODUCTION
$ 11 99 each
SS-T066 ULTRA STRUCTURE OF ANIMAL CELLS
SS-T067 DIGESTIVE SYSTEM SET
SS-T068 CIRCULATORY SYSTEM SET
SS-T069 CENTRAL NERVOUS SYSTEM
SS-T071 ENDOCRINE SYSTEM
SS-T072 RESPIRATORY SYSTEM SET
SS-T073 SMOKING AND HEALTH
SS-T077 THE ROOT OF A FLOWERING PLANT
SS-T078 THE STEM OF A FLOWERING PLANT
SS-T079 THE LEAF OF A FLOWERING PLANT
SS-T080 THE FLOWER OF A FLOWERING PLANT
SS-T081 CHROMOSOMES & GENES IN ACTION
SS-T084 FERN LIFE CYCLE SET
SS-T092 MEIOSIS SET
SS-T095 HUMAN BLOOD SET
SS-T097 VIRUS SET
SS-T098 ECOLOGY UNDER MICROSCOPE
SS-T101 INTRO TO THE WORLD OF THE MICROSCOPE
SS-T102 CELLS PLANTS/ ANIMAL
SS-T104 HOW A ONE CELLED ANIMAL DEVIDES
SS-T105 HARMFUL AND HELPFUL BACTERIA
SS-T107 EGG TO TADPOLE TO FROG
SS-T112 YOUR LIFE AND BREATH
SS-T115 HOW ROCKS ARE FORMED
SS-T119 GREEN PLANTS SET
SS-T121 YOUR BODY SET
SS-T123 YOUR GLANDS
SS-T124 DRUGS AND NUTRITION
SS-T126 LIFE IN THE SEA
SS-T130 INTRODUCTION TO SPACE
SS-T202 PROTOZOA SET
SS-T203 LIFE FUNCTIONS OF PARAMECIA
SS-T204 B ODY DEFENSES/INFECTION
SS-T207 MICROSCOPE - A TOOL FOR LEARNING
SS-T210 MONOCOTS & DICOTS SET
Microslide Viewer - This is a precision instrument for viewing Microslides. Simply insert and focus. The Viewer brings 5X magnifications into focus, allowing every image to be seen exactly as if observed through a microscope under ideal conditions.


Microslide and Lesson Plans Each Microslide is a set of 8 related 35 mm images photographed through a microscope. Arrows and call outs help the students locate important features. Each Microslide is accompanied by a detailed text folder designed to simulate, inform and question the student about the topic under study. Each text folder has a pocket in which the Microslide is stored.
SS-T212 SYMBIOSIS SETMICROSLIDE - VIEWER
SS-T213 THE KINGDOM MANERA
SS-T214 KINGDOM FUNGI SET
SS-T215 MARINE BIOLOGY SET
SS-T216 MARINE PLANKTON
SS-T217 TAXONOMY OF BACTERIA
SS-T221 NERVE & MUSCLE ACTION SET
SS-T222 THE KINGDOWM PROTISTA
SS-T223 SKELETAL SYSTEM
SS-T229 IMMUNITY
SS-T230 CELL MEMBRANE
SS-T239 PLANT KINGDOM SET
SS-T240 HUMAN DISEASES
SS-T241 FIVE KINGDOMS SET
SS-T245 CANCER SET
SS-T248 CELL NUCLEUS
SS-T249 BASIC HUMAN HISTOLOGY
SS-T251 HUMAN FETAL DEVELOPMENT
SS-T252 DROSOPHILA
SS-T254 LIFE IN THE DESERT
SS-T256 MONARCH BUTTERFLY
SS-T257 MEALWORM
SS-T259 CYTOPLASM
SS-T263 MOLLUSKS
SS-T272 FROG
SS-T302 ROCKS/ROCK FORMING MINERALS
SS-T306 MINERAL CHARACTERISTICS & IDENTIFICATION
SS-T312 FOSSILS & ECOLUTION
SS-T313 STARS
SS-T408 GALAXIES & NEBULAE
SS-T410 MOON
Each chart is 8.5” x 11” two sided, protected in a plastic sleeve, 3 hole punched for convenience. An information sheet is included.
Brain/Heart

These handy IN-A-BOX sets each contain 20 specimens. All varieties are individually bagged and described, covering a given ecosystem.


Identification Series sets display 16 individual mounts with tab labels and descriptive backing for each variety. Housed in a bin for quick reference and minimal classroom storage space.

Investigate a leaf structure with this model of a lima bean leaf. Magnified 45x. Detailing the transverse and longitudinal sections. The mesophyll includes palisade and spongy parenchyma. Both surfaces are shown with stomas and guard cells. There is additional detail of the xylem, phloem, and vascular veins.
Constructed of durable plastic. Comes with a detailed key.


Explore plant anatomy using this Monocot Stem Model. Anatomy features are displayed in longitudinal and cross sections, including the cuticle layer, epidermis, closed vascular bundles, parenchymataous tissue and several others. Comes with a detailed key. Hand-painted. 16x16.5x5”
Modeled after a sunflower, this Dicot Stem Model is an excellent tool for learning plant anatomy. The epidermis, cork layer, phloem region, cambium xylem region, pith and other vital structures are all visible. Anatomy is displayed in cross, radial and tangential sections. Comes with a detailed key. Hand-painted. 13.5” x 7” x 6”

Cube includes:
1 reusable plastic snap box
8 large petri dishes
8 small petri dishes
8 swabs
1 packet nutrient agar
1 exploration guide
SS-PH96004-S3 $29.99
SS-B12674A-SP......................$59.99

SS-B12812......................$37.99

Jumbo petri dish is used to culture bacteria or other microorganism. Big enough to place a child’s hand. This plastic petri dish is made of polystyrene. 150mmD
Sterile and individually packed.
SS-CH10931-S3
SS-CH10928-S3
SS-CH10934/1-S3
SS-CH10934/2-S3
SS-CH10934/3-S3
SS-CH10934/4-S3
$1.79
$8.99 Plastic Petri Dish, set of 3, w Agar
$3.79 Plastic Petri Dish, 35mmD 10/pk
$5.39 Plastic Petri Dish, 60mmD, 18/pk
$6.69 Plastic Petri Dish, 70mmD, 18/pk
$7.79 Plastic Petri Dish, 90mmD, 20/pk
Explore the astounding world of owls with this exceptional kit that includes two owl pellets* (additional pellets are available, if desired), nesting tubes, wooden probes, forceps, a hand lens, a 6” ruler, a information sheets, and a 16 page STEAM interactive Activity Book. So, what is an owl pellet?
LS-AO18 $40.50

Animal
Arachnida FN-A228L $18.95




















































































Muscular System ..................................................
Muscular System Giant Chart 42*62
Female Muscular System
Skeletal System ....................................................
Skeletal System Giant Chart 42*62
Anatomy and Injuries of the Spine
Vertebral Column
Understanding Osteoporosis
Human Spine Disorders
Human Skull
Head and Neck
Whiplash Injuries of the Head and Neck
Anatomy and Injuries of the Head and Neck
Shoulder and Elbow .............................................
Anatomy and Injuries of the Shoulder
Joints of the Lower Extremities
Joints of the Upper Extremities.............................
Knee Injuries
Athletic Injuries of the Knee
Hip and Knee ........................................................
Anatomy and Injuries of the Hip
Hip and Knee Inflammations
Hand and Wrist
Understanding Carpal Tunnel Syndrome
Anatomy and Injuries of the Hand and Wrist ........
Ligaments of the joints
Foot and Ankle
Anatomy and Injuries of the Foot and Ankle .........
Understanding Low Back Pain
Understanding Pain
Migraines & Headaches
Understanding Alzheimer’s Disease 9976 $24.99
Understanding Schizophrenia 6423 $24.99
Understanding Major Depressive Disorder........... 9974 $24.99
Understanding Epilepsy 9867 $24.99
Lymphatic System 8937 $24.99
Vascular System and Viscera ............................... 8952 $24.99
Peripheral Artery Disease 0013 $24.99
Anatomy of the Heart 9878 $24.99
The Heart 8023 $24.99
Heart Conditions 8824 $24.99
Heart Failure 9963 $24.99
Heart Disease 9912 $24.99
Cardiovascular Disease 9915 $24.99
Not all titles are pictured.



































numbered charts are 20” x 26” they have metal eyelets at top corners for hanging or portable stand display, plastic lamination for durability and write on/wipe off surface.
Understanding Influenza
Understanding Coronavirus Disease 2019 (COVID-19) .....






Ear
Eye
Temporomandibular
Anatomy of the Teeth 9931 $24.99
Disorders of the Teeth and Jaw 9866 $24.99


Male Reproductive System.................................................
Sexually Transmitted Infections

























numbered charts are 20” x 26” they have metal eyelets at top corners for hanging or portable stand display, plastic lamination for durability and write on/wipe off surface.











Teach students all about the periodic table in a fun & engaging way! Book includes sorting games, information about different elements & 2 sheets of magnets to help aid the learning process. The engaging element of this book means students will enjoy reading this book over and over again. Made from high quality, responsibly sourced materials.








Our layer puzzles are a fun, educational tool to learning how an egg turns into a butterfly, ladybird, frog and honeybee. Piece together and discover each lifecycle stage as you pull away each layer. Each puzzle has four lift out layers. Made from responsibly sourced materials.




















FUN & ADDICTIVE - Not only is flipping the Human Anatomy Study Cube as addictive as a fidget spinner, but it’s also an incredibly fun and intriguing way to revise anatomy. ADVANCED ANATOMY - With each flip you’ll discover a new part of the human body and be able to revise anatomy in-depth using all the detailed information 7x7x7cm cube!

STUDY 9 DIFFERENT BODY PARTS - The eye, ear, heart, lungs, brain, skin, digestive system, muscles & bones and circulatory system.


Chart books are a great way to get all the charts you need


Elementary
Elementary
Elementary
Elementary
Elementary









Muscular and Skeletal Systems
Lightweight,

978-0-7817-7678-3
Anatomy of the Heart
978-0-7817-7681-3 $10.95
Anatomy of the Brain
978-0-7817-7683-7 $10.95
Spinal Nerves and the Autonomic Nervous System
978-0-7817-7684-4 ...................................................................... $10.95
Circulatory System
978-0-7817-7685-1 $10.95
Anatomy and Disorders of the Respiratory System
978-0-7817-7686-8 ...................................................................... $10.95
Anatomy and Disorders of the Digestive System
978-0-7817-7688-2 ...................................................................... $10.95
• These popular study guides feature a new look, updated content and improved organizational features. The durable, folding format means that our most popular anatomical images are portable for the on-thego student. Guides show numbered anatomical structures and contain answers that can be concealed for easy self-testing and memorization. Write-on/wipe-off laminated surface.
• Folded size: 9“x 4“, unfolded size: 9“x 24“
Show how the lungs are emptied and filled with air by relaxation and contraction of the diaphragm muscle! Two balloons attached to a Y tube simulate the lungs. The chest cavity is represented by a half gallon plastic bell jar with an open top and stout rubber sheet which acts as a diaphragm. As the diaphragm is pulled downward, the atmospheric pressure is lowered inside the chamber causing the lungs to expand, taking in air. When the diaphragm is released, the lungs deflate. Includes lesson plan.
8.25” x 8.25” x 8.25”
SS-B12116-SP $67.99

Disarticulated Skeleton with Skull.................................... AC-CHA5/1
Half Disarticulated Skeleton with Skull AC-CHA4/1 $111.99
Bucky Skeleton ................................................................
Painted Bucky Skeleton...................................................
Numbered Bucky Skeleton
Skeleton Stand ................................................................
Mr Super Skeleton AC-A-13
Mr Flexible Skeleton AC-A-15
Mr Plain Skeleton ............................................................
Mr Thrifty Skeleton AC-WCP-1
Painted Mr Thrifty ............................................................
AC-WCP-85 $107.99
Bart Skeleton ................................................................... AC-CH95 $182.99
Flexible Mr Thrifty Skeleton with Spinal Nerves
Painted Big Tim Skeleton ................................................
Tiny Tim Skeleton
Muscle Spine with Disorders ...........................................
AC-WCP-1NX $96.99
AC-CMS65 $56.99
AC-CMS-1 $29.99
AC-CH5900 $207.99
Soft Disc Vertebral Column ............................................. AC-Z4009 $337.99
Spine Stand
Vertebral Column .............................................................
AC-SM91
$26.99
AC-CH-59X $104.99



Desk-Size Vertebral Column
Lumbar Vertebrae ............................................................
AC-CS-85X $59.99
AC-CH-LS-4 $32.99
Flexible Cervical Vertebral Column ................................. AC-A72 $96.99
Flexible Lumbar Vertebral Column with Herniated Disc
AC-A-76/5 $126.99
Flexible Lumbar Vertebral Volumn................................... AC-A74 $104.99
Lumbar Vertebrae with Interchangeable Discs
5th Cervical Vertebra
Atlas/Axis with 3rd Cervical Vertebrae............................. AC-Z4083 $73.99
Skull AC-CS-20 $36.99
Classic Skull .................................................................... AC-A20 $114.99
Two Part Skull
Skull with Cervical Vertebrae on Stand
AC-CH-S2 $30.99
AC-CS-20V $59.99
Functional Model of the Shoulder Joint ........................... AC-NS-53
Functional Shoulder Joint Model AC-A80
Shoulder Joint with Detachable Ligaments ..................... AC-Z4550 $107.99
Functional Model of the Elbow Joint ................................ AC-NS-52 $248.99
Functional Elbow Joint Model
AC-A83 $99.99

Functional Model of the Hip Joint
Functional Hip Joint Model ..............................................
AC-NS-51
Hip Joint with Detachable Ligaments ..............................
Functional Knee Joint
Functional Knee Joint Model ...........................................
Muscles of the Hand
Elastic Hand ....................................................................
Painted Hand ...................................................................
Functional Foot & Ankle
Foot Model Set ................................................................
Elastic Foot
Painted Foot
Peter/Petra Torso .............................................................
Functional Francis Torso
Dapper Dan Torso ...........................................................
Little Joe Torso
Tall Paul Torso
Brain ................................................................................
Demonstration Brain
2-Part Brain .....................................................................
Brain with Arteries............................................................
$274.99
AC-A81 $99.99
AC-Z4554 $107.99
AC-NS-50 $263.99
AC-A82
AC-NS13
$102.99
$859.99
AC-OS32E $103.99
AC-OS32P $136.99
AC-NS55 $789.99
AC-CHM312 $98.99
AC-OS31E $104.99
AC-OS31P $139.99
AC-CMT-3 $81.99
AC-CMT-32 $442.99
AC-CMT-2 $81.99
AC-CMT-4 $45.99
AC-CMT-5 $249.99
AC-CH-1 $42.99


Color-Coded Eight Part Brain AC-240R $399.99
Skull with Eight Part Brain ...............................................
Miniature Skull with 8-Part Brain
Jumbo Heart ....................................................................
Heart ...............................................................................
AC-MO-12C $74.99
AC-WCPSB $30.99
Basic Heart AC-G8 $91.99
Whopper Eye ...................................................................
Cataract Eye
Ear ...................................................................................
Female Pelvis with Femur Heads ....................................
Pelvis and pelvic floor
Injection teaching model ..................................................
Larynx with Tongue
Disestive Track
Skin..................................................................................
Flossing & Brushing
Gaint Brush......................................................................

AC-CH2 $57.99
AC-CS22 $819.99
AC-E10 $154.99
AC-Z4058F $119.99
AC-267A $551.99
AC-A26200 $143.99
AC-GS4 $439.99
AC-JS22 $869.99
SS-B12150 $43.99
AC-W5314 $62.99
AC-W5355 $25.99

















more information or pictures of the models not shown here please visit our website. Button - Dream
Button - Chocolate
CT-BFD-C9 Magnet - Sh*t Happens
CT-MO-C3 Magnet - Life Gives Lemons
Print - Baking a Cake.............................
.......CT-PM-C1 Print - Honey Bee
CT-PM-C10 Print - Not So Fungi
Print - Medicinal Botany.........................
Print - Just Desserts
Print - Tea Party
Print - Cocktail Party ..............................
Print - Herb Garden
Print - Spice Rack
Print - Fruit Basket .................................
Print - All the Feels
.......CT-PM-C12
.......CT-PM-C4
R280
R287
R513
R501
R500
R275
R290
R340 Ecological Relationships Display Mount
R218




Bio Corporation works hard to maintain pricing. In the event of a price change we will publish the new price online. Customers will be contacted about the change and have the options to accept, change or cancel.
United Parcel Service (UPS) Ground will be used as the carrier for most orders. Next Day Air, Second Day Air or Three Day Select are available at additional cost. Please note that additional charges will apply for shipments to Hawaii and Alaska.
In general, shipping can be estimated at 20% of your order total with a minimum charge of $14.00. All shipping costs are the responsibility of the customer.

Call 1-800-222-9094
Monday through Friday 8:00am - 5:00pm CST. info@biologyproducts.com



